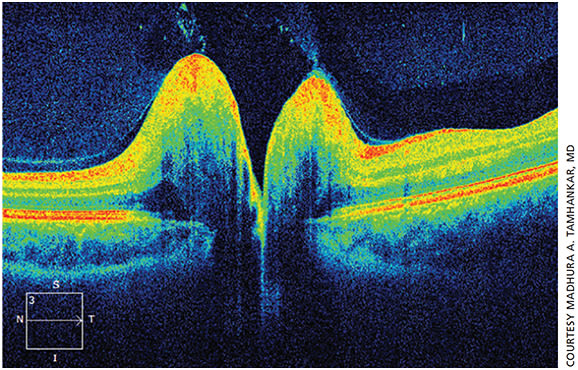
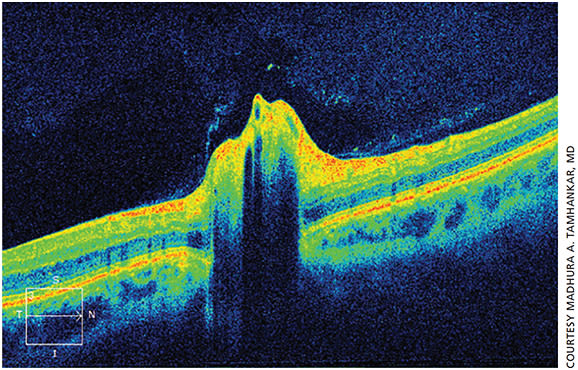

The papilledema dilemma
Learn how to diagnose papilledema from pseudopapilledema — one can result in vision loss.
By Madhura A. Tamhankar, MD
Papilledema is swelling of the optic nerve head due to increased intracranial pressure. The retinal ganglion cells axons, comprising the nerve fiber layer, become swollen from the increased intracranial pressure causing optic nerve head swelling. Papilledema can occur from structural lesions such as large tumors, vascular abnormalities, venous sinus thrombosis, and arteriovenous fistulae causing an increase in the intracranial pressure.
The more common condition under which papilledema occurs is idiopathic intracranial hypertension (IIH) or pseudo-tumor cerebri. IIH typically occurs in young, overweight females and is diagnosed based on symptoms that include headaches, transient visual obscurations and may be accompanied by a recent history of weight gain.
The incidence of IIH has increased in parallel with the obesity epidemic, so there’s a chance comprehensive ophthalmologists will often be faced with a patient who presents with the above signs and symptoms and is found to have papilledema. Approximately 86% of the IIH patients experience some degree of vision loss and 10% can develop severe vision loss.1 Therefore, discovering papilledema in the office warrants timely evaluation and management; neuro-imaging and spinal fluid analyses, along with measuring the opening pressure at the time of lumbar puncture, helps to establish the etiology of the papilledema.
Pseudopapilledema, on the other hand, is a benign condition in which elevation of the optic nerve head is observed in the absence of intracranial structural abnormalities. Most often this is due to visible or buried optic nerve head drusen. However, pseudopapilledema can also be present without presence of optic nerve head drusen. This condition is benign and typically requires monitoring alone. In some patients, visual field loss can occur due to drusen.
To diagnose papilledema, clinical history and careful funduscopic exam to determine the characteristics of elevated disc swelling is essential. The Frisen scale is an accepted objective method to evaluate papilledema ophthalmoscopically and to quantify the amount of nerve swelling.2 While it is useful to grade the swelling, it lacks sensitivity in detecting changes (for the better or for the worse) and can display inter-observer variability. Visual fields need to be performed to determine the extent of vision loss.
There are times, however, when it is challenging to distinguish between papilledema and pseudopapilledema especially when the degree of disc-swelling is mild.3 Patients who have buried optic nerve head drusen, which are calcified hyaline bodies that reside within the optic nerve, or have pseudopapilledema without optic nerve head drusen may be misdiagnosed as having true papilledema.
Ancillary testing can often help to distinguish between the two entities. Tests that can help clinicians decide between papilledema and pseudo-papilledema include fluorescein angiography, fundus auto fluorescence, orbital ultrasonography, optical coherence tomography (OCT) and neuro-imaging such as CT and MRI.3,4
I will discuss the utility of orbital ultrasonography and OCT as ancillary tests to distinguish between papilledema and pseudopapilledema in the section below.
Orbital ultrasonography
Orbital ultrasonography is a rapid, cost-effective and minimally invasive procedure that has wide application in ophthalmology. It is an important tool that can not only help to detect optic nerve head drusen, but can also detect dilation of retrobulbar optic nerve sheath fluid which may indicate true disc swelling. High-frequency probes (10 MHZ) are used for ophthalmic ultrasound. When sound waves strike the intraocular structures and reflect back, that signal is converted to an image. This is especially helpful when the nerve head drusen are buried. Optic nerve head drusen appear as hyper-reflective on B-scan when they are present within the optic nerve head (Figure 1).

Figure 1. Longitudinal B scan showing optic nerve head drusen (arrow).
In true papilledema, increased intracranial pressure (ICP) is transmitted along the subdural space within the optic nerve. Using B-scan ultrasonography, one can detect a widening of the optic nerve sheath diameter due to the presence of increased fluid within the nerve sheath. This can indicate true papilledema (Figure 2). Studies have shown high levels of correlation between optic nerve sheath width by ultrasonography and ICP measured directly through invasive monitors.5

Figure 2. Cross sectional B-scan showing optic nerve in cross section (white arrow) and distended nerve sheath fluid (black arrow).
When optic nerve sheath fluid is detected, a 30-degree test can be performed which is very helpful to detect fluid. During this test, the A-scan, placed in the dynamic mode, measures the width of the optic nerve in primary gaze and again as the patient shifts his gaze 30° away from primary position and abducts the eye. In cases of increased ICP, the nerve and nerve sheath are stretched and subarachnoid fluid distributes fairly evenly over the nerve. This will result in a measurement less at 30° than seen in primary gaze. If the nerve enlargement is due to parenchymal infiltration or thickening of the optic nerve sheath, the measurement will not change as the globe abducts from primary position.
The presence of optic nerve sheath fluid may indicate true papilledema. The cerebrospinal fluid pressure increases within the perioptic space causing optic nerve head elevation. Orbital ultrasonography was shown to be 90% sensitive in detecting true papilledema and 79% specific for pseudopapilledema. That is, about one in five patients with pseudopapilledema may have dilated nerve sheaths.4 This underscores the importance of obtaining a careful history and examination in all patients with elevated optic nerves in order to decide if a further work up is warranted.
The high false positives noted in this study show that the absence of optic nerve sheath fluid is reassuring when clinically pseudopapilledema is suspected, while the presence of fluid can be found with pseudopapilledema due to variable optic nerve sheath compliance. Such patulous nerve sheaths can also be noted on MRI scans in patients without elevated ICP.
The drawbacks of orbital ultrasonography are that the technology is not readily available in every clinic and typically an experienced ultrasonographer is needed to interpret the findings.
Optical coherence tomography
OCT has gained widespread popularity in ophthalmology for providing a cross-sectional image of the retinal nerve fiber layer, the optic nerve and the macula. Recent studies have shown that OCT measurement of the peripapillary retinal nerve fiber layer (RNFL) thickness provides quantitative assessment that correlates with Frisen grading of papilledema and correlates with visual function.6 Other recent studies have shown that OCT can help distinguish between true papilledema and pseudopapilledema, monitor changes in the disc swelling over time and contribute to understanding the consequences of prolonged optic disc swelling and visual loss.7,8
Spectral-domain OCT is superior to that of time-domain OCT for providing three-dimensional reconstruction of the retina and optic nerve head. It gives us better details to quantify the physiologic changes within the RNFL and optic nerve head in patients with disc elevation.
An NIH study looked at the efficacy of using acetazolamide along with weight loss compared to weight loss alone as treatment for patients with idiopathic intracranial hypertension. Various parameters of OCT such as peripapillary RNFL, total retinal thickness, optic nerve head volume and elevation, and the ganglion cell–inner plexiform layer complex (GCL–IPL) thickness were used to evaluate patients with IIH having mild to moderate disc swelling.7,8 The study found that these parameters correlated well with the Frisen grading for papilledema when 3-D segmentation algorithm was used.
Several studies have addressed the utility of OCT in differentiating pathologic edema from optic nerve head drusen. When the drusen are buried within the substance of the optic nerve, the optic nerve margin may appear to be indistinct. The OCT shows a “lumpy bumpy” internal contour in pseudopapilledema versus a smooth internal contour seen in papilledema (Figures 3 and 4). Calcified drusen may appear as reflective areas above the RPE. However, OCT may not always show the presence of noncalcified drusen, which may not show any altered reflective characteristics. Moreover, optic nerve head blood vessels can sometimes be misinterpreted as drusen.9-12
Figure 3. OCT of the optic nerve head showing smooth inner contour as seen in true papilledema.
Figure 4. OCT of the optic nerve head showing a “lumpy bumpy” internal contour as seen in pseudopapilledema.
Patients with anomalous or crowded optic nerves who do not have drusen are difficult to distinguish from true papilledema. The optic nerve head elevation may look similar to true papilledema. RNFL thickness and total retinal thickness are parameters that may be helpful, although challenges still exist when trying to differentiate between the two entities when a milder degree of disc swelling is present.6,13
Another important marker of true papilledema is the inward bowing of Bruch’s membrane due to the pressure gradient between the retrolaminar perioptic nerve sheath and the vitreous cavity of the globe.
In cases when distinction between papilledema and pseudopapilledema may be challenging, following the optic nerve with OCT parameters such as RNFL thickness, total retinal thickness, optic nerve head volume and looking for changes in these parameters may help to identify true papilledema from pseudopapilledema. In the latter case no changes would be observed over a follow-up period. With true papilledema, on the other hand, one would expect to observe changes in these parameters.
Conclusion
More work is needed to understand the role of OCT in assessing papilledema and analyzing which parameters are reliable, reproducible and sensitive to detect change in the optic nerve swelling.14
Current recommendations for distinguishing papilledema from pseudopapilledema should include a careful optic nerve examination and documenting appearance of the optic nerve via fundus photography in patients who present with disc elevation. When the suspicion of papilledema is high based on clinical history, patients should undergo neuro-imaging, preferably MRI of the brain with and without contrast and a lumbar puncture to measure opening pressure.
Pseudopapilledema can be observed with fundus photographs taken at baseline — the fundus appearance of the optic nerve should remain stable and not change during follow-up. Orbital ultrasonography is also very useful when available and helps to detect optic disc drusen and retrobulbar optic nerve sheath fluid.
In addition, OCT can be immensely useful to corroborate the diagnosis and has future implications in monitoring papilledema and evaluating therapy in those with visual dysfunction due to IIH. Currently, the most useful OCT-derived features relevant to papilledema are optic disc volume, subretinal fluid, buried disc drusen and thickness of the retinal ganglion cell layer. OM
REFERENCES
1. Wall M, George D. Idiopathic intracranial hypertension. A prospective study of 50 patients. Brain. 1991;114(Pt 1A):155-180.
2. Frisén L. Swelling of the optic nerve head: a staging scheme. J Neurol Neurosurg Psychiatry. 1982;45:13-18.
3. Atta HR. Imaging of the optic nerve with standardised echography. Eye (Lond). 1988;2(Pt 4):358-366.
4. Carter SB, Pistilli M, Livingston KG, et al. The role of orbital ultrasonography in distinguishing papilledema from pseudopapilledema. Eye (Lond). 2014;28:1425-1430.
5. Rajajee V, Vanaman M, Fletcher JJ, Jacobs TL. Optic nerve ultrasound for the detection of raised intracranial pressure. Neurocrit Care. 2011;15:506-515.
6. Scott CJ, Kardon RH, Lee AG, Frisén L, Wall M. Diagnosis and grading of papilledema in patients with raised intracranial pressure using optical coherence tomography vs clinical expert assessment using a clinical staging scale. Arch Ophthalmol. 2010;128:705-711.
7. OCT Sub-Study Committee for NORDIC Idiopathic Intracranial Hypertension Study Group, Auinger P, Durbin M, et al. Baseline OCT measurements in the idiopathic intracranial hypertension treatment trial, part II: correlations and relationship to clinical features. Invest Ophthalmol Vis Sci. 2014;55:8173-8179.
8. OCT Sub-Study Committee for NORDIC Idiopathic Intracranial Hypertension Study Group, Auinger P, Durbin M, et al. Baseline OCT measurements in the idiopathic intracranial hypertension treatment trial, part I: quality control, comparisons, and variability. Invest Ophthalmol Vis Sci. 2014;55:8180-8188.
9. Bassi ST, Mohana KP. Optical coherence tomography in papilledema and pseudopapilledema with and without optic nerve head drusen. Indian J Ophthalmol. 2014;62:1146-1151.
10. Johnson LN, Diehl ML, Hamm CW, Sommerville DN, Petroski GF. Differentiating optic disc edema from optic nerve head drusen on optical coherence tomography. Arch Ophthalmol. 2009;127:45-49.
11. Lee KM, Woo SJ, Hwang JM. Differentiation of optic nerve head drusen and optic disc edema with spectral-domain optical coherence tomography. Ophthalmology. 2011;118:971-977.
12. Sarac O, Tasci YY, Gurdal C, Can I. Differentiation of optic disc edema from optic nerve head drusen with spectral-domain optical coherence tomography. J Neuroophthalmol. 2012;32:207-211.
13. Skau M, Milea D, Sander B, Wegener M, Jensen R. OCT for optic disc evaluationin idiopathic intracranial hypertension. Graefes Arch Clin Exp Ophthalmol. 2011;249:723-730.
14. Kardon R. Optical coherence tomography in papilledema: what am I missing? J Neuroophthalmol. 2014;34 Suppl:S10-17.
About the Author | |

| Madhura A. Tamhankar, MD, is an assistant professor of Ophthalmology at the Hospital of the University of Pennsylvania in Philadelphia. |








